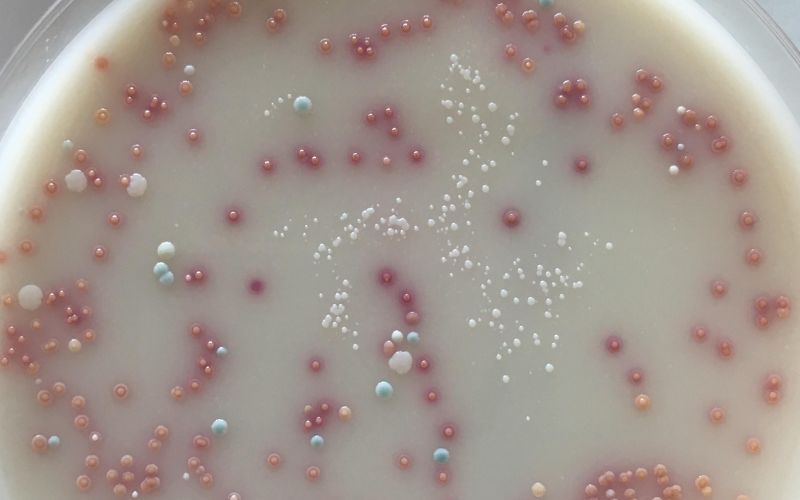
Tụ cầu khuẩn là nguyên nhân phổ biến nhất gây lẹo mắt

Tốt nghiệp Đại học Dược Hà Nội, với hơn 10 năm kinh nghiệm trong lĩnh vực Dược phẩm. Hiện là giảng viên giảng dạy các môn Dược lý, Dược lâm sàng,...
Mỹ Hạnh
05/11/2025
Mặc định
Lớn hơn
Lẹo mắt không chỉ gây sưng, đỏ và đau nhức ở vùng mắt, mà nếu không được điều trị kịp thời còn có thể dẫn đến nhiễm trùng lan rộng, ảnh hưởng đến thị lực và sinh hoạt hằng ngày. Vì vậy, việc nhận biết sớm các dấu hiệu bị lẹo mắt và thăm khám kịp thời là rất quan trọng để phòng ngừa biến chứng và giúp mắt nhanh chóng hồi phục.
Thông thường, lẹo mắt là tình trạng nhẹ và có thể tự khỏi sau vài ngày mà không cần can thiệp y tế. Tuy nhiên, trong một số trường hợp, lẹo có thể kéo dài, sưng to hoặc lan sang vùng khác của mí mắt, gây đau rát và khó chịu, lúc này người bệnh cần được thăm khám và điều trị bởi bác sĩ chuyên khoa. Do đó, hãy cùng Nhà thuốc Long Châu tìm hiểu dấu hiệu bị lẹo mắt và biết khi nào cần đi khám để giúp bạn chủ động xử lý, giảm thiểu đau đớn và tránh những biến chứng không mong muốn.
Lẹo mắt là một bệnh lý khá phổ biến, nhưng không phải ai cũng hiểu rõ về nguyên nhân và đặc điểm của nó. Đây là tình trạng nhiễm khuẩn khu trú tại vùng mí mắt, khiến khu vực này bị sưng, đỏ và đau. Dân gian thường gọi là “mụt lẹo” hoặc “mụt mắt”. Mặc dù lẹo mắt không ảnh hưởng nghiêm trọng đến sức khỏe vì chủ yếu là bệnh ngoài da, nhưng nó gây ra cảm giác đau nhức, khó chịu, đồng thời ảnh hưởng đến thẩm mỹ và sinh hoạt hàng ngày.
Thông thường, lẹo mắt xuất hiện ở chân lông mi, nổi rõ trên da và có thể xuất hiện ở một hoặc cả hai mắt, tại mí trên hoặc mí dưới. Một trong những triệu chứng khiến người bệnh khó chịu nhất là tình trạng mưng mủ. Phần mủ này chính là nhân của mụt lẹo, trông giống như một nốt mụn viêm ở vùng mí mắt. Nếu không được chăm sóc đúng cách, mụt lẹo có thể vỡ sớm, gây nhiễm trùng lan rộng, tái phát nhiều lần, để lại sẹo hoặc thậm chí dẫn đến biến chứng nặng hơn.
Dựa trên vị trí và tuyến bị viêm, lẹo mắt được chia thành ba loại chính:
Nhận biết đúng loại lẹo và chăm sóc kịp thời sẽ giúp quá trình điều trị diễn ra hiệu quả, hạn chế biến chứng và ngăn ngừa tái phát.
Dấu hiệu đầu tiên và dễ nhận biết nhất của lẹo mắt là sự xuất hiện của một khối u nhỏ, màu đỏ, mềm và gây đau ở gần bờ mí mắt - vị trí nơi các sợi lông mi mọc. Trong một số trường hợp, cục lẹo có thể hình thành ở mặt trong của mí mắt, trông giống như một nốt mụn nhọt nhỏ gây cảm giác cộm, khó chịu mỗi khi chớp mắt.
Khối u này thường to dần theo thời gian và có thể chuyển sang màu trắng hoặc vàng do hình thành mủ bên trong. Khi hệ miễn dịch của cơ thể hoạt động tốt và kiểm soát được tình trạng nhiễm trùng, mụt lẹo có thể tự vỡ, chảy mủ ra ngoài và dần biến mất trong thời gian ngắn.

Vùng da xung quanh mí mắt thường có biểu hiện sưng đỏ rõ rệt, kèm theo cảm giác ngứa râm ran hoặc căng tức khó chịu. Ở một số người, khu vực này còn trở nên nhạy cảm hơn bình thường, chỉ cần chạm nhẹ cũng thấy đau hoặc rát. Khi lẹo tiến triển nặng, mí mắt có thể sưng phồng, khiến việc mở mắt, chớp mắt trở nên khó khăn và gây ảnh hưởng đến sinh hoạt hàng ngày.
Khi bị lẹo mắt, người bệnh có thể nhận thấy mắt tiết ra một lượng dịch bất thường hoặc chảy nước mắt nhiều hơn bình thường, tuy nhiên thị lực hầu như không bị ảnh hưởng. Một số trường hợp còn có cảm giác như có dị vật trong mắt gây cộm rát và khiến mắt trở nên nhạy cảm hơn với ánh sáng.
Việc hiểu rõ các dấu hiệu đặc trưng của lẹo mắt giúp bạn dễ dàng phân biệt với những bệnh lý về mắt khác. Cụ thể:
Nhận biết đúng tình trạng sẽ giúp bạn có hướng xử lý phù hợp, tránh điều trị sai cách gây ảnh hưởng đến mắt.
Tụ cầu khuẩn, đặc biệt là Staphylococcus aureus, là nguyên nhân phổ biến nhất gây ra lẹo mắt. Khi vi khuẩn xâm nhập vào các tuyến bã nhờn hoặc nang lông mi, chúng sẽ gây viêm nhiễm, tạo thành mụt lẹo sưng đỏ và đau. Bên cạnh đó, lẹo mắt cũng có thể xuất hiện như một biến chứng của tình trạng viêm bờ mi mạn tính, khi vùng mí bị viêm kéo dài làm tăng nguy cơ lan rộng vi khuẩn.
Một số nhóm đối tượng có nguy cơ cao mắc lẹo mắt bao gồm:

Hiểu rõ các yếu tố nguy cơ này giúp bạn chủ động hơn trong việc phòng ngừa, bảo vệ sức khỏe đôi mắt và hạn chế tái phát lẹo.
Lẹo mắt gây sưng đau, khó chịu và ảnh hưởng đến sinh hoạt hằng ngày. Khi phát hiện dấu hiệu lẹo, bạn nên đến cơ sở y tế để được thăm khám và điều trị đúng cách, tránh tự ý nặn hoặc dùng thuốc bừa bãi.
Điều trị lẹo mắt gồm:

Lẹo mắt hoàn toàn có thể điều trị dứt điểm nếu được phát hiện sớm và tuân thủ đúng hướng dẫn của bác sĩ. Bài viết trên đã giúp bạn nhận biết các dấu hiệu đặc trưng của bệnh cũng như cách điều trị lẹo mắt. Để rút ngắn thời gian hồi phục và bảo vệ thị lực, bạn nên chủ động thăm khám sớm và thực hiện nghiêm túc phác đồ điều trị được chỉ định.
Dược sĩ Đại họcNguyễn Thanh Hải
Tốt nghiệp Đại học Dược Hà Nội, với hơn 10 năm kinh nghiệm trong lĩnh vực Dược phẩm. Hiện là giảng viên giảng dạy các môn Dược lý, Dược lâm sàng,...